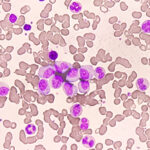
Bexobrutideg Produces Rapid and Durable Responses in CLL

Digital Platform Has Early Success in Managing Rare Blood Disorder
A team from Italy shared their experience integrating a digital health platform to improve care of patients suspected to have acquired hemophilia A (AHA)....
Study: Obinutuzumab Safe and Effective in Relapsed or Refractory Follicular Lymphoma
Final results of a phase 2 trial confirmed a favorable risk-benefit profile of zanubrutinib plus obinutuzumab (ZO) in patients with relapsed or refractory follicular...
Institution Describes Challenges after Release of Commercial Formulation of Hydroxyurea
The availability of a commercial formulation of hydroxyurea will provide uninterrupted access to many pediatric patients with sickle cell disease (SCD) and Medicaid insurance,...
Bexobrutideg Produces Rapid and Durable Responses in CLL
New data on bexobrutideg show that the treatment produced rapid and durable responses in patients with relapsed or refractory chronic lymphocytic leukemia (CLL) who...